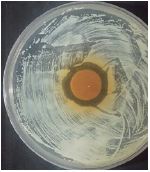
https://cdn.apub.kr/journalsite/sites/ktappi/2017-049-06/N0460490601/images/JKTAPPI_2017_v49n6_5_t003-5.jpg
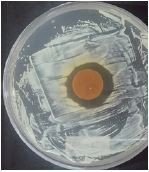
https://cdn.apub.kr/journalsite/sites/ktappi/2017-049-06/N0460490601/images/JKTAPPI_2017_v49n6_5_t003-10.jpg

1. 서 론
생활환경 수준의 발달로 인한 건강에 대한 국민적 인식수준이 높아짐에 따라 식품, 생활용품 등 포장소재의 물리적, 화학적 품질요건에 대한 소비자의 관심도 점점 증가하고 있다.1) 이에 따라 국외에서는 식품포장지에 대한 관리규격으로 포장재의 원료 및 첨가제에 대한 규제가 이루어지고 있다. 특히 포장분야의 선진국에서는 음식과 직접적으로 접촉되어 인체에 영향을 끼칠 수 있는 것을 간접식품첨가물로 규정하고 이에 대한 안전성 평가가 시행되고 있다. 하지만 국내에서는 포장용기에 대한 기준과 규격을 정한다는 규정만 존재하며 간접식품첨가물과 같은 그 외 별도의 규제는 이루어지지 않고 있는 실정이다.2)
현재 포장재와 관련하여 식품에 접촉될 수 있는 물질로는 종이 및 판지 원재료뿐만 아니라 식품보존제, 접착제, 코팅성분, 인쇄재료 등이 있다. 제지업계에서는 이러한 물질들을 이용해 식품이나 포장지에 부가적인 특성을 부여하며 외부 위험인자로부터 포장물을 보호해 왔다.3) 국내 식품포장업계에서는 미생물로부터 식품의 변패를 방지하기 위해 폴리에틸렌과 같은 플라스틱 필름을 포장재 표면에 적용하거나 합성 식품보존제를 첨가함으로서 지류포장재로서 높은 점유율을 차지하고 있다.4) 그러나 최근에는 환경 규제의 강화로 인해 기존의 방법을 탈피한 생분해성 친환경소재를 적용한 포장원지 연구가 많이 진행되고 있으며, 그 일환으로 인체무해한 항균제나 필름을 이용해 식품을 신선하게 유지시키기 위한 지속적인 노력이 이루어지고 있다.5-7)
식품 항균제는 합성항균제와 천연항균제로 분류되며 제지산업에서는 지료조성 공정이나 가공 공정에 첨가하여 사용되고 있다. 합성항균제의 사용은 천연 항균제와 마찬가지로 외부오염물질로부터 식품을 보호하며 식중독 등을 방지할 수 있는 장점이 있지만 천연항균제와는 달리 제조공정에 있어 환경오염을 유발할 수 있는 단점도 있다.8) 또한, 합성항균제는 식품 중의 미생물과 작용하여 보존효과를 나타내기 때문에 인체 내 잠재적인 유해요인으로 보고되고 있으며, 첨가 사용량에 대한 엄격한 규제가 이루어지고 있다. 이에 반해 천연항균제의 경우 대부분 식물에서 유래되는 페놀릭 성분으로 이루어져 주로 우수한 항균성을 지니며, 정확한 항균 메커니즘은 알려져 있지 않지만 일반적으로 항균성분이 세포막 투과성을 변질시켜 세포용해를 유도하거나 세포벽 합성 억제를 통해 세균을 사멸시킨다고 알려져 왔다.9) Choi 등10)은 천연항균 추출물과 관련하여 녹차 추출물 중 카테킨 성분 농도에 따른 항균활성 비교 연구를 통해 천연 추출물의 항균효과에 대한 유효성을 확인하였으며, Lee 등5)은 천연추출물의 보존성과 관련해 녹차 추출물을 첨가한 단백질 필름의 물성 및 어묵에 대한 산패억제 효과를 탐색한 바 있다.
녹차는 오래전부터 우리가 쉽게 접할 수 있는 음료수로 평소 건강기능 식품으로서 애용되어 왔다. 녹차에서 유래되는 폴리페놀 물질은 대부분이 카테킨 형태로 그 함량은 30-40%에 달하는데, 이 카테킨 성분이 박테리아의 지질 이중층에 붙어 박테리아의 막에 손상을 주어 항균효과를 나타내게 된다. 또한, 폴리페놀은 대장균과 같은 Gram(-)의 경우 세포막 외부의 지질 다당류와 폴리페놀 성분이 음전하를 띄기 때문에 항균성분이 접근하기는 어렵지만, Staphylococcus aureus(S. aureus) 같은 Gram(+)은 PBP2'의 합성을 억제함으로서 항균효과가 우수하다고 보고되고 있다.11)
이와 같이 천연추출물을 이용해 포장산업에 적용하고 고부가가치화하기 위해서는 최저 농도에서도 높은 균 증식 억제효과가 발현될 수 있어야 하며 합성항균제보다 우수한 안정성을 지님으로서 경제적으로 그 실용성을 입증할 필요가 있다. 그러나 친환경적 식품포장용지라는 트렌드에만 부합하려 할 뿐 천연항균제의 이용 방법 면에서는 현재까지 그 연구가 미비한 실정이다.
본 연구에서는 이러한 추출항균제를 이용해 식품의 독성에 대한 문제가 발생하지 않도록 포장재 표면에 처리하여 항균성능을 평가하였다. 천연항균제의 효율적 활용을 위해 다양한 유기용매를 이용해 추출한 녹차 내 폴리페놀 수율을 검토하였고 추출조건에 따른 정량방법은 Folin-Ciocalteu method12)를 적용하였다. 또한, 추출한 항균제를 종이표면에 분산시키기 위해 carboxymethyl cellulose(CMC) sodium salt를 사용했다. 셀룰로오스로 부터 유도된 음이온 고분자 전해질인 CMC는 종이의 강도를 향상시키는 지력증강제로 알려져 있지만 표면 처리 시 필름상태로 성형되기 때문에 가식성 필름용도로 활용되기도 하며 분산시키고자 하는 성분을 안정적으로 전달하는 전달체로도 이용된다.13) 이에 CMC가 처리된 종이의 특성을 살펴보고자 인장지수, 인열지수, 투기도 등의 물리적 특성을 분석하였으며, 최종적으로 항균물질 첨가농도에 따른 항균효과를 확인하기 위해 halo test와 shake flask 분석을 실시하였다.
2. 재료 및 방법
2.1 공시재료
본 실험에서 사용된 펄프는 표백 크라프트펄프(BKP)와 미표백 크라프트펄프(UKP)로 450 mL CSF의 여수도 수준으로 조절하기 위해 실험실용 Valley beater로 고해를 실시하였다. 고해된 펄프는 0.3% 이하로 희석하여 사용하였다. 또한, 천연항균제를 추출하기 위한 재료로는 D사에서 구입한 국내산 100% 녹차가루를 사용하였으며, 추출용 유기용매로는 아세톤, 메탄올, 에탄올을 이용하였다.
2.2 녹차의 열수추출
녹차파우더를 이용한 열수추출은 분말 15 g에 유기용매 100 mL를 혼합해 60℃에서 3시간 동안 추출한 뒤 진공 여과기를 통과시켜 제조하였다. 이상의 과정을 2회 반복하였으며, 유기용매에 의한 추출조건을 Table 1에 나타냈다.
Table 1.
Extraction conditions of antimicrobial agents from green tea
| Organic solvent | Organic solvent ratio, %(v/v) |
|---|
| Ethanol | 50 | 80 |
| Methanol |
| Acetone |
2.3 천연항균제 추출물 조제 및 항균지 제조
천연항균물을 추출한 뒤 rotary evaporator를 이용하여 농축한 후 환류냉각기를 통해 분말 형태의 최종 녹차추출물을 제조하였다. 제조된 추출물을 종이 표면에 처리하기 위해 CMC를 이용하였으며 CMC 대비 추출물 농도는 0, 10, 50, 100 mg/mL로 준비했다. 4종류의 추출물 농도 조건은 auto bar coater(# 44)로 평량 80 g/m2의 수초지에 도포되었으며, 이에 대한 대조군으로서 무처리 원지를 비교하였다. 제조된 도포액은 Fig. 1과 같다.

Fig. 1.
CMC coating solutions with green tea extracts.
2.4 Total polyphenol 함량의 분석
녹차 추출물의 총 폴리페놀 함량은 AOAC(Association of Official Analytical Chemists)의 Folin-Ciocalteu method를 부분적으로 수정하여 측정 하였다. 녹차추출물 1 mL를 취해 10 mL volume flask에 증류수 5 mL와 함께 추가한 후 0.5 mL의 Folin-Ciocalteu 시약과 혼합하여 3분간 방치하였다. 반응 후 5 g/L의 Na2CO3를 1.5 mL 추가하여 전체 부피가 10 mL가 되도록 했으며, 시료가 들어있는 플라스크는 밀봉하여 항온수조기에서 50°C로 16분간 유지한 후 냉각하여 765 nm에서 흡광도를 측정하였다. 총 페놀함량은 gallic acid(0-100 mg/L)를 이용해 작성한 표준곡선으로 gallic acid로 환산하여 나타냈다. 총 폴리페놀 수율의 경우 각 조건에서 최종적으로 얻어진 고형분의 무게와 고형분 내 폴리페놀 함량을 이용해 사용된 녹차시료의 원료량에 대한 백분율(%)로 나타냈다.
2.5 항균성 평가
사용된 균주는 Gram positive인 S. aureus(ATCC 6538)로서 K사로부터 균주를 분양 받아 사용하였다. 이들 균을 위한 배지 제조를 위해 Tryptic Soy Broth-(TSB, Difco, USA)와 Tryptic Soy Agar(TSA, Difco, USA)를 사용하였다. 평판 배지 TSA 배지조제는 TSB 배지에 agar 1.5% 첨가 후 auto clave(1 atm, 121°C)에서 20분간 멸균하여 petri dish에 적당량을 분주하여 사용하였다.
2.5.1 Paper disk method
Agar plate에 4×108 CFU/mL의 S. aureus균 혼탁액을 100 μL씩 접종한 후 유리봉을 이용해 도말하였다. 항균지 시편을 균이 도말된 표면에 접촉시킨 후 37°C 조건에서 배양시켰으며 18시간 후 시편 표면에 발생하는 clear zone을 mm 단위로 측정하였다.
2.5.2 Shake flask method
제조된 항균지를 지름 16 mm로 재단 후 균이 배양된 액체 배지와 함께 35°C, 100 rpm 조건으로 일정시간 동안 shaking 과정을 거쳤으며, 시험관에서는 각각 100 μL씩 채취하여 고체 배지에 분주 후 균수를 측정하였다. 항균액 처리에 따른 정균감소율은 Eq. 1을 이용하여 산출하였다.
where, A = Number of colonies before shaking,
B = Number of colonies after 1 hour shaking.
2.6 포장용지의 물리적 특성 측정
항균제 첨가 CMC가 포장용지에 미치는 영향을 확인하고자 auto bar coater(# 44)를 이용하여 제조된 CMC 1%, 3%, 5%, 7%, 10% 용액을 수초지(80 g/m2) 표면에 도포하였다. 도포된 시험편은 KS M ISO 187에 의거하여 23±1°C 상대습도 50±2%의 조건에서 24시간 동안 조습처리한 후 인장강도(KS M ISO 1924-2), 인열강도(KS M ISO 1974), 투기도(KS M ISO 5636-3)를 측정하였고 측정값은 평량에 따른 지수로 나타냈다.
3. 결과 및 고찰
3.1 녹차추출물 내 총 폴리페놀 함량
Fig. 2는 총 폴리페놀 함량을 측정하기 위해 gallic acid를 이용해 0 ppm에서 100 ppm까지 농도를 조절 한 후 작성한 검량선이다. 검량선의 기울기는 0.0062, y절편은 0.003이며 상관계수는 0.9797을 나타냈다.

Fig. 2.
Calibration curve of polyphenol contents by gallic acid.
Fig. 3은 녹차를 유기용매별로 추출한 후 Fig. 2에 나타낸 검량선을 이용해 총 폴리페놀 수율을 검토한 결과이다. 추출 후 최종적으로 얻은 고형분 내 폴리페놀 함량은 Table 2에 나타냈으며, 이를 이용해 총 폴리페놀 수율을 계산하였다.

Fig. 3.
Total polyphenol yields of green tea extracted by organic solvents.
Table 2.
Polyphenol contents in solids extracted by organic solvents
| Polyphenol contents1), μg per 100 μg |
|---|
| Ethanol | Methanol | Acetone |
|---|
| 50% solvent | 56.3 (29.8)2) | 54.8 (20.4) | 74.2 (23.9) |
| 80% solvent | 55.7 (22.6) | 54.4 (23.6) | 64.7 (24.6) |
총 폴리페놀 수율은 아세톤 50% > 에탄올 50% > 아세톤 80% > 에탄올 50% > 메탄올 80% > 메탄올 50% 순으로 높게 나타났으며, 이는 추출용매의 극성이 강해짐에 따라 유효성분의 용출이 용이해 진다는 연구 결과들과 유사한 경향을 나타냈다. 아세톤과 에탄올의 경우 유기용매에 대한 물의 혼합비율이 높아질수록 폴리페놀 수율이 높아졌으며 이러한 결과는 Shin 등14)이 발표한 물과 유기용매가 혼합될 경우 페놀성 물질의 용출이 용이해진다는 결과와 매우 유사한 결과를 나타냈으며, Nihal15)의 홍차와 마테차에 대한 유효성분 추출 시 아세톤과 에탄올이 높은 수율을 나타낸다는 결과와 일치했다.
반면 메탄올의 경우 폴리페놀 수율이 50%에서 80%로, 추출용매가 비극성일수록 유효성분 수율이 더 높게 나타났다. 이는 상기의 결과와 상반된 결과를 나타내기 때문에 결론적으로 소재에 대한 용매의 극성이 용출되는 폴리페놀의 용해도를 달리하며, 폴리페놀 화합물과 같은 유효성분이나 용출량에 영향을 미치는 것으로 판단된다. 이러한 결과는 Mohammedi 등16)에 의한 연구에서처럼 물과 혼합한 추출용매의 극성변화가 폴리페놀 화합물이나 분자량, 다른 구성성분 함량에 따라 다르게 영향을 받는다는 보고와 일치했다.
3.2 녹차추출물 처리농도에 따른 항균성 평가
3.2.1 Paper disk법에 의한 항균활성
Table 3은 녹차추출물 처리농도에 따라 제조된 종이를 paper disk법에 의해 항균성 평가를 실시한 결과로 4×108 CFU/mL의 균 혼탁액이 도말된 배지에 항균종이를 접촉한 후 나타나는 clear zone을 측정하였다.17)
항균성의 경우 시험편에 도포될 때 녹차추출물의 첨가농도가 10 mg/mL 이하로 처리된 시험편이나 처리되지 않은 시험편 모두 균 성장을 저해하는 효과가 나타나지 않았으며 CMC 용액 내 녹차추출물이 50 mg/mL 이상 처리된 시험편에서는 항균활성을 나타내는 clear zone을 확인할 수 있었다. 처리 시험편의 경우 리그닌 함량에 기인하여 항균활성이 다르게 나타날 수 있다고 판단하여 리그닌 함량이 적은 BKP와 리그닌 함량이 상대적으로 많은 UKP를 비교하였다. 50 mg/mL의 추출물이 처리된 UKP 시험편에서 23 mm, BKP 시험편에서는 26 mm의 clear zone이 측정되었으며 100 mg/mL이 처리된 시험편에서는 26 mm 이상의 강한 항균력을 보이는 clear zone이 측정되었다.
UKP의 경우 종이 시험편에 일정한 농도 이상의 항균액이 처리됨에 따라 항균효과가 증가하였으며, 이는 녹차추출물 내 폴리페놀류 성분농도에 따른 항균활성이 향상된다는 Choi 등10)의 연구결과와 유사하였다. 50 mg/mL이 처리된 UKP 시험편과 BKP 시험편은 22-26 mm의 비교적 우수한 항균 범위 내에서 나타났으며, 각각 23 mm, 26 mm로 측정되었다. 하지만 본 실험은 도말한 균 배지에 종이가 접촉함으로서 나타나는 정성분석으로서 3 mm라는 미세한 차이를 기준으로 시험편에 따른 항균성을 비교분석 하기에는 적합하지 않다고 판단되었으며, 보다 정확한 비교를 위해서 균수감소율을 통한 정량분석을 실시하였다.
3.2.2 Shake flask method에 의한 균 생장 저해율
Fig. 4는 녹차추출물 처리농도에 따라 제조된 종이를 shake flask method를 통해 항균성 평가를 실시한 결과이다. Shake flask method는 균이 배양된 액체 배지에 종이시험편을 일정 시간 동안 노출시켜 항균작용에 의해 감소하는 균수를 측정하는 정량분석이다. 그 결과 녹차추출물 처리된 시험편의 최대 균 생장 저해율은 89.1%를 나타냈다. 이는 항균추출물이 처리되지 않은 BKP 시험편과 15-20% 이상의 차이를 나타냈으며 UKP 시험편의 경우 균 생장 저해율 차이가 크게 나타나지 않았다. 이는 UKP 시험편의 자체 항균성이 높게 나타나 추출물에 의한 상승 폭이 작게 나타난 것으로 사료된다. 본 연구에서는 시험편의 원료제조 과정에 있어서 잔존하는 리그닌18)이 항균활성에 미세하게 영향을 준다는 것을 증명할 수는 없었지만 동일조건에서 UKP 시험편이 항균성 발현에 있어서 유리하게 작용한 것으로 사료된다. 이는 Lee 등19)이 연구한 분리된 폴리페놀계 리그닌이 세포 용해를 유도하거나 박테리아의 세포막을 손상시킴으로서 항균 효과를 나타낸다는 결과를 미루어 보아 시험편의 원료성분에 따라 항균 특성이 다르게 나타날 가능성을 확인할 수 있었다.

Fig. 4.
The reduction rates of bacteria cell in coated paper according to the concentration of antimicrobial extracts.
3.3 표면처리 시 CMC 농도에 따른 원지 물성 평가
Fig. 5는 CMC를 종이 표면에 처리함에 따라 형성된 도포막 특성을 살펴보기 위한 투기도 결과이다. 투기도의 경우 표면 처리된 CMC의 농도가 높아질수록 투과되는 공기량이 미미하게 감소하는 결과를 보였다. 이는 CMC가 수분에 대한 저항성이 약하고 극성이 큰 작용기가 많은 결과로서 처리농도를 증가함에 따라 공기 차단효과가 향상된 것으로 사료된다. Figs. 6 및 7은 CMC를 항균제와 함께 처리함에 있어서 CMC 농도에 따라 변화하는 종이의 인장지수 및 인열지수를 나타낸 결과이다. Fig. 6의 인장지수는 CMC 처리농도가 5%까지 증가할수록 높아졌으며, 이러한 결과는 CMC가 보강처리 재료로서 종이강도 개선에 효과적이라고 나타낸 Kim 등20)의 연구결과와 유사하였다. 또한, 종이의 강도는 처리보강제의 점도에 따라 영향을 받는다는 점을 미루어 보아 적절한 유동성을 지닌 CMC가 종이 공극에 침투함으로서 섬유간 결합력을 향상시킨 것으로 사료되며 5% 이상으로 처리될 경우에는 CMC가 종이 공극 내에 침투하지 못하고 표면에 잔류함으로써 강도적 특성이 감소한 것으로 판단된다. 또한, Fig. 7에 나타난 인열지수에서도 유사한 경향을 보였다.

Fig. 5.
Changes in air permeability according to the concentrations of CMC solution.

Fig. 6.
Changes in tensile index according to the concentrations of CMC solution.

Fig. 7.
Changes in tear index according to the concentrations of CMC solution.
4. 결 론
항균성이 우수한 폴리페놀의 수율을 높이기 위해 녹차 분말을 이용하여 극성이 다른 유기용매를 추출하였으며 Folin-Ciocalteu method를 이용한 총 폴리페놀 함량을 나타냈다. 유기용매와 물의 혼합비율에 따라서 변칙적인 수율을 나타냈지만 아세톤, 에탄올, 메탄올 순서로 상대적으로 높은 추출 수율을 확인했으며, 메탄올을 제외한 극성이 높은 물의 혼합비율이 많아짐에 따라 폴리페놀 용해도 또한 증가하였다.
녹차추출물의 처리농도에 따른 시편의 항균성은 10 mg/mL를 기점으로 추출물이 함량이 증가함에 따라 clear zone의 지름이 증가했으며 항균추출물이 처리된 BKP 시험편에 대해서는 균의 성장을 약 15-20% 정도 저해하였다.
녹차추출물이 첨가된 CMC의 최적 코팅조건을 탐색하기 위해 종이 물성을 살펴본 결과 인장지수와 인열지수는 각각 5% CMC와 3% CMC를 기점으로 강도적 특성이 증가하다가 감소하는 경향을 나타냈다. 또한, 투기도의 경우 CMC의 처리함에 따라 감소하는 결과를 나타냈으며 공기 차단성이 향상되는 것을 확인할 수 있었다.
Acknowledgements
본 논문은 2017년 국민대학교 교내 연구비 지원에 의하여 수행되었습니다.
Literature Cited
C. Byrd-Bredbenner, J. Berning, J. Martin-Biggers and V. Quick, International Journal of Environmental Research and Public Health,
Food safety in home kitchens: A synthesis of the literature,
10(9); 4060-4085 (2013)
Byrd-Bredbenner, C., Berning, J., Martin-Biggers, J., and Quick, V., Food safety in home kitchens: A synthesis of the literature, International Journal of Environmental Research and Public Health 10(9):4060-4085 (2013)
10.3390/ijerph10094060J. S. Kim, Health - Welfare Policy Forum,
Management of food packaging plastics in selected countries and its implications for Korea,
231; 116-136 (2016)
Kim, J. S., Management of food packaging plastics in selected countries and its implications for Korea, Health - Welfare Policy Forum 231:116-136 (2016)
H. C. Yu and Y. H. Cho, Food Science and Industry,
US food packaging system and management status,
30(3); 164-174 (1997)
Yu, H. C. and Cho, Y. H., US food packaging system and management status, Food Science and Industry 30(3):164-174 (1997)
J. H. Lee, J. H. Lee and J. M. Park, Journal of Korea TAPPI,
Manufacture of antimicrobial paper using food preservative,
33(2); 81-86 (2001)
Lee, J. H., Lee, J. H., and Park, J. M., Manufacture of antimicrobial paper using food preservative, Journal of Korea TAPPI 33(2):81-86 (2001)
S. H. Lee, M. S. Lee, S. K. Park, D. H. Bae and S. D. Ha, Journal of the Korean Society of Food Science and Nutrition,
Physical properties of protein films containing green tea extract and its antioxidant effect on fish paste products,
33(6); 1063-1067 (2004)
Lee, S. H., Lee, M. S., Park, S. K., Bae, D. H., and Ha, S. D., Physical properties of protein films containing green tea extract and its antioxidant effect on fish paste products, Journal of the Korean Society of Food Science and Nutrition 33(6):1063-1067 (2004)
10.3746/jkfn.2004.33.6.1063M. K. Lee, S. M. Lee and D. H. Oh, Journal of Korea TAPPI,
Manufacture of antimicrobial paper for food products,
33(1); 65-71 (2000)
Lee, M. K., Lee, S. M., and Oh, D. H., Manufacture of antimicrobial paper for food products, Journal of Korea TAPPI 33(1):65-71 (2000)
G. O. Lim, Y. H. Hong and K. B. Song, Korean Journal of Food Preservation,
Preparation of gelatin film containing grapefruit seed extract and its antimicrobial effect,
16(1); 134-137 (2009)
Lim, G. O., Hong, Y. H., and Song, K. B., Preparation of gelatin film containing grapefruit seed extract and its antimicrobial effect, Korean Journal of Food Preservation 16(1): 134-137 (2009)
S. H. Yoon, T. K. Kim, M. K. Kim, Y. J. Lim, N. S. Yoon and Y. S. Lee, J. Korean Soc. Dyers & Finishers,
Antimicrobial finishing of cotton fabrics using gallnut extracts,
15(6); 27-32 (2003)
Yoon, S. H., Kim, T. K., Kim, M. K., Lim, Y. J., Yoon, N. S., and Lee, Y. S., Antimicrobial finishing of cotton fabrics using gallnut extracts, J. Korean Soc. Dyers & Finishers 15(6):27-32 (2003)
S. A. Hayek, G. Rabin, A. I. Salam and A. Mendez-Vilas (ed.), vol. 2. Antimicrobial natural products, In Microbial Pathogens and Strategies for Combating Them: Science, Technology and Education; 910-921, Spain. Formatex Research Center. (2013)
Hayek, S. A., Rabin, G., and Salam, A. I., Antimicrobial natural products, In Microbial Pathogens and Strategies for Combating Them: Science, Technology and Education, Mendez-Vilas, A. (ed.), vol. 2, Formatex Research Center, Spain, pp. 910-921 (2013)
K. M. Choi, Y. G. Yun, J. H. Jiang, S. S. Oh, H. D. Yang, H. J. Kim, B. H. Jeon and H. Park, Korean J. Oriental Physiology & Pathology,
Studies on the comparison of antibacterial activity by catechin concentration in green tea extract,
19(5); 1233-1237 (2005)
Choi, K. M., Yun, Y. G., Jiang, J. H., Oh, S. S., Yang, H. D., Kim, H. J., Jeon, B. H., and Park, H., Studies on the comparison of antibacterial activity by catechin concentration in green tea extract, Korean J. Oriental Physiology & Pathology 19(5):1233-1237 (2005)
J. M. Lorenzo and P. E. S. Munekata, Asian Pacific Journal of Tropical Biomedicine,
Phenolic compounds of green tea: Health benefits and technological application in food,
6(8); 709-719 (2016)
Lorenzo, J. M. and Munekata, P. E. S., Phenolic compounds of green tea: Health benefits and technological application in food, Asian Pacific Journal of Tropical Biomedicine 6(8):709-719 (2016)
10.1016/j.apjtb.2016.06.010C. Y. Lee, K. M. Kim and H. S. Son, Korean Journal of Food Science and Technology,
Optimal extraction conditions to produce rosemary extracts with higher phenolic content and antioxidant activity,
45(4); 501-507 (2013)
Lee, C. Y., Kim, K. M., and Son, H. S., Optimal extraction conditions to produce rosemary extracts with higher phenolic content and antioxidant activity, Korean Journal of Food Science and Technology 45(4):501-507 (2013)
10.9721/KJFST.2013.45.4.501H. Krizova and J. Wiener, Autex Research Journal,
Development of carboxymethyl cellulose/polyphenols gels for textile applications,
13(2); 33-36 (2013)
Krizova, H. and Wiener, J., Development of carboxymethyl cellulose/polyphenols gels for textile applications, Autex Research Journal 13(2):33-36 (2013)
10.2478/v10304-012-0021-9S. L. Shin and C. H. Lee, J. of Life Science,
Antioxidant activities of ostrich fern by different extraction methods and solvents,
21(1); 56-61 (2011)
Shin, S. L. and Lee, C. H., Antioxidant activities of ostrich fern by different extraction methods and solvents, J. of Life Science 21(1):56-61 (2011)
10.5352/JLS.2011.21.1.56N. Turkmen, S. Ferda and Y. Sedat Velioglu, Food Chemistry,
Effects of extraction solvents on concentration and antioxidant activity of black and black mate tea polyphenols determined by ferrous tartrate and Folin-Ciocalteu methods,
99(4); 835-841 (2006)
Turkmen, N., Ferda, S., and Sedat Velioglu, Y., Effects of extraction solvents on concentration and antioxidant activity of black and black mate tea polyphenols determined by ferrous tartrate and Folin-Ciocalteu methods, Food Chemistry 99(4):835-841 (2006)
10.1016/j.foodchem.2005.08.034Z. Mohammedi and F. Atik, Int. J. Pharma Bio Sci,
Impact of solvent extraction type on total polyphenols content and biological activity from Tamarix aphylla (L.) Karst,
2; 609-615 (2011)
Mohammedi, Z. and Atik, F., Impact of solvent extraction type on total polyphenols content and biological activity from Tamarix aphylla (L.) Karst, Int. J. Pharma Bio Sci 2:609-615 (2011)
E. K. Jo, Antibacterial effect of food poisoning bacteria using natural extracts, Republic of Korea. University of Youngnam. (2014)
Jo, E. K., Antibacterial effect of food poisoning bacteria using natural extracts, Master’s Thesis, University of Youngnam, Republic of Korea (2014)
Y. S. Kim, S. J. Kim and B. H. Yoon, Journal of Korea TAPPI,
Use of additives in peroxide bleaching with unbleached kraft pulp,
32(1); 79-85 (2000)
Kim, Y. S., Kim, S. J., and Yoon, B. H., Use of additives in peroxide bleaching with unbleached kraft pulp, Journal of Korea TAPPI 32(1):79-85 (2000)
E. S. Lee, Y. J. Song and S. S. Lee, Antimicrobial property and biodegradability of lignin nanofibers, Republic of Korea. Yonsei University. (2014)
Lee, E. S., Song, Y. J., and Lee, S. S., Antimicrobial property and biodegradability of lignin nanofibers, Master’s Thesis, Yonsei University, Republic of Korea (2014)
K. J. Kim, M. H. Lee and T. J. Eom, Journal of Korea TAPPI,
Strengthening treatment of aged Hanji with water soluble polymers,
43(5); 1-10 (2011)
Kim, K. J., Lee, M. H., and Eom, T. J., Strengthening treatment of aged Hanji with water soluble polymers, Journal of Korea TAPPI 43(5):1-10 (2011)